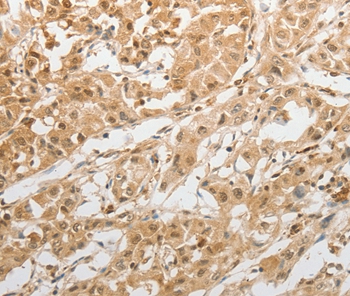

![Progesterone Receptor(PR501), Biotin conjugate, 0.1mg/mL [26628-22-8] Progesterone Receptor(PR501), Biotin conjugate, 0.1mg/mL [26628-22-8]](https://biotium.com/wp-content/uploads/2016/12/BNUB0501-0-1.jpg)
Progesterone Receptor(PR501), Biotin conjugate, 0.1mg/mL [26628-22-8]
BNCB0501
ApplicationsImmunoHistoChemistry, ImmunoHistoChemistry Paraffin
Product group Antibodies
ReactivityBovine, Human, Mouse
TargetGRIN2C
Overview
- SupplierBiotium
- Product NameProgesterone Receptor(PR501), Biotin conjugate, 0.1mg/mL [26628-22-8]
- Delivery Days Customer9
- ApplicationsImmunoHistoChemistry, ImmunoHistoChemistry Paraffin
- CAS Number26628-22-8
- CertificationResearch Use Only
- ClonalityMonoclonal
- Clone IDPR501
- Concentration0.1 mg/ml
- ConjugateBiotin
- Gene ID2905
- Target nameGRIN2C
- Target descriptionglutamate ionotropic receptor NMDA type subunit 2C
- Target synonymsGluN2C, NMDAR2C, NR2C, glutamate receptor ionotropic, NMDA 2C, GluN2C(alt_5'UTR_77nt), GluN2C(alt_5'UTR_87nt), GluN2C(del_e2), GluN2C-b alternative isoform, N-methyl D-aspartate receptor subtype 2C, N-methyl-D-aspartate receptor subunit 2C, glutamate [NMDA] receptor subunit epsilon-3, glutamate receptor, ionotropic, N-methyl D-aspartate 2C, putative NMDtranscript(altAcc_e11), putative NMDtranscript(altDon_e4), putative NMDtranscript(del_e4)
- HostMouse
- IsotypeIgG1
- Protein IDP06401
- Protein NameProgesterone receptor
- Scientific DescriptionThis MAb is specific to progesterone receptor and shows minimal cross-reaction with other members of the family. Progesterone receptor is expressed as two major isoforms, PR-A (81 kDa) and PR-B (116 kDa). Expression of PgR has been suggested to reflect a intact estrogen regulatory machinery and therefore, predict better clinical response to endocrine therapy than ER alone.Primary antibodies are available purified, or with a selection of fluorescent CF® Dyes and other labels. CF® Dyes offer exceptional brightness and photostability. Note: Conjugates of blue fluorescent dyes like CF®405S and CF®405M are not recommended for detecting low abundance targets, because blue dyes have lower fluorescence and can give higher non-specific background than other dye colors.
- SourceAnimal
- ReactivityBovine, Human, Mouse
- Storage Instruction2°C to 8°C,RT
- UNSPSC41116161